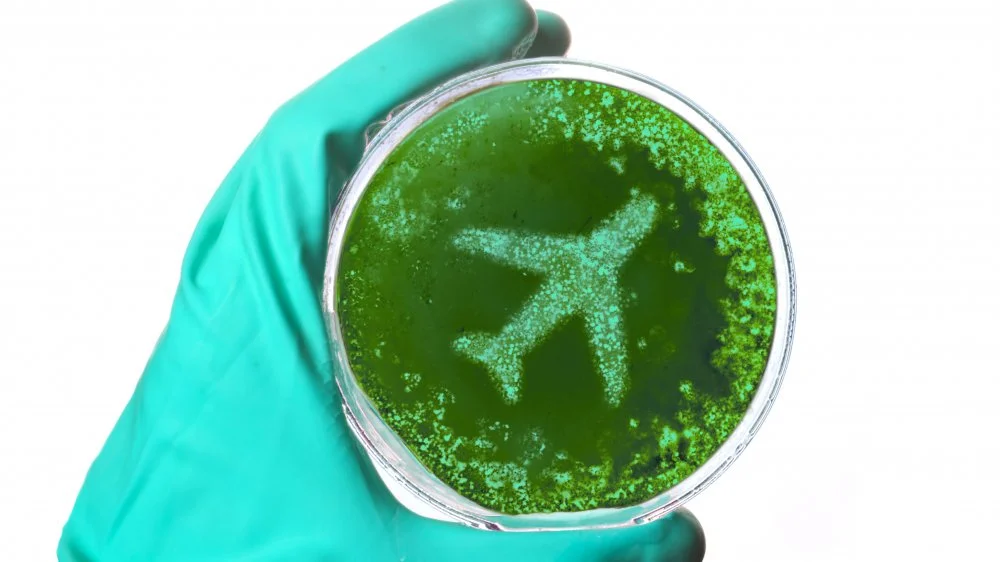
Le coin le plus sale d'un avion : une surprise inattendue !

Analyse scientifique des surfaces à bord

Poursuivant l’examen sous l’angle scientifique, il est facile d’imaginer qu’un avion, lieu confiné et traversé par des centaines de passagers, devienne rapidement un réservoir de saletés et de microbes. Des incidents à bord illustrent parfois à quel point l’environnement peut être désagréable, mais ce sont surtout les analyses systématiques qui révèlent l’ampleur du phénomène. Comprendre quelles surfaces concentrent le plus de micro-organismes aide à mieux cibler les gestes d’hygiène pendant un vol.

On pourrait logiquement soupçonner les toilettes d’être le coin le plus sale d’un avion, mais plusieurs études montrent le contraire. Les lieux où l’on mange se révèlent souvent plus contaminés, car ils reçoivent un flux constant de mains, d’aliments et d’objets. Des prélèvements effectués sur des vols court-courriers ont mis au jour des éléments inattendus dans les poches des sièges — objets usagés et déchets — et, surtout, des traces microbiennes significatives sur de nombreuses surfaces.
Parmi les observations clés :
- Les plateaux-repas des sièges présentent une densité de colonies bactériennes nettement supérieure à celle des toilettes.
- Des agents détectés comprennent Escherichia coli, des levures, des moisissures et d’autres bactéries communes, parfois responsables d’infections ou de troubles digestifs.
- Des virus respiratoires et des agents gastro-intestinaux (norovirus) ont été retrouvés sur certaines surfaces, ainsi que des staphylocoques résistants connus pour provoquer des infections cutanées.
Concrètement, ces résultats invitent à la prudence : éviter de poser directement son repas sur le plateau sans l’avoir nettoyé, se laver les mains fréquemment et limiter le contact inutile avec les surfaces partagées réduisent le risque d’exposition. En gardant ces gestes simples, on atténue l’impact du coin le plus sale d’un avion sur sa santé personnelle.